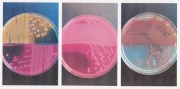
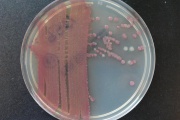
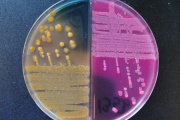
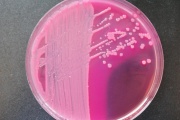

Uppladdningar av Magnus Thore
Hoppa till navigering
Hoppa till sök
Den här specialsidan visar alla filer som laddats upp.
| Datum | Namn | Miniatyrbild | Storlek (byte) | Beskrivning | Versioner |
|---|---|---|---|---|---|
| 9 maj 2012 kl. 22.16 | Yersinia1.jpg (fil) |  |
184 kbyte | 1 | |
| 9 maj 2012 kl. 22.15 | Tbe.jpg (fil) |  |
786 kbyte | 1 | |
| 9 maj 2012 kl. 22.15 | Viralameningo2.jpg (fil) |  |
600 kbyte | 1 | |
| 9 maj 2012 kl. 22.14 | Viralameningo1.jpg (fil) | 184 kbyte | 1 | ||
| 9 maj 2012 kl. 22.14 | Vhf.jpg (fil) |  |
482 kbyte | 1 | |
| 9 maj 2012 kl. 22.14 | Vibrio.jpg (fil) |  |
242 kbyte | 1 | |
| 9 maj 2012 kl. 22.13 | Vre.jpg (fil) |  |
359 kbyte | 1 | |
| 9 maj 2012 kl. 22.13 | Tyfoid.jpg (fil) |  |
335 kbyte | 1 | |
| 9 maj 2012 kl. 22.12 | Tuberkulos.jpg (fil) |  |
753 kbyte | 1 | |
| 9 maj 2012 kl. 22.12 | Trikinos.jpg (fil) |  |
307 kbyte | 1 | |
| 9 maj 2012 kl. 22.11 | Syfilis2.jpg (fil) |  |
1,39 Mbyte | 1 | |
| 9 maj 2012 kl. 22.11 | Syfilis1.jpg (fil) |  |
505 kbyte | 1 | |
| 9 maj 2012 kl. 22.10 | Stelkramp.jpg (fil) |  |
451 kbyte | 1 | |
| 9 maj 2012 kl. 22.10 | Sorkfeber.jpg (fil) |  |
391 kbyte | 1 | |
| 9 maj 2012 kl. 21.11 | Kikhosta.jpg (fil) |  |
524 kbyte | 1 | |
| 9 maj 2012 kl. 21.11 | Htlv.jpg (fil) |  |
330 kbyte | 1 | |
| 9 maj 2012 kl. 21.10 | H1n1.jpg (fil) |  |
793 kbyte | 1 | |
| 9 maj 2012 kl. 21.10 | Hiv.jpg (fil) |  |
1,07 Mbyte | 1 | |
| 9 maj 2012 kl. 21.09 | Hepatite.jpg (fil) |  |
353 kbyte | 1 | |
| 9 maj 2012 kl. 21.09 | Hepatitd.jpg (fil) |  |
297 kbyte | 1 | |
| 9 maj 2012 kl. 21.08 | Hepatitc2.jpg (fil) |  |
1,27 Mbyte | 1 | |
| 9 maj 2012 kl. 21.08 | Hepatitc1.jpg (fil) |  |
605 kbyte | 1 | |
| 9 maj 2012 kl. 21.07 | Hepatitb2.jpg (fil) |  |
806 kbyte | 1 | |
| 9 maj 2012 kl. 21.06 | Hepatitb1.jpg (fil) |  |
476 kbyte | 1 | |
| 9 maj 2012 kl. 21.06 | Hepatita.jpg (fil) |  |
313 kbyte | 1 | |
| 9 maj 2012 kl. 21.05 | Harpest.jpg (fil) |  |
515 kbyte | 1 | |
| 9 maj 2012 kl. 20.23 | Ekinokock.jpg (fil) |  |
679 kbyte | 1 | |
| 9 maj 2012 kl. 20.22 | Giardia.jpg (fil) |  |
450 kbyte | 1 | |
| 9 maj 2012 kl. 20.22 | Fågelinfluensa.jpg (fil) |  |
418 kbyte | 1 | |
| 9 maj 2012 kl. 20.21 | Ehec2.jpg (fil) |  |
300 kbyte | 1 | |
| 9 maj 2012 kl. 20.20 | Ehec1.jpg (fil) |  |
1,02 Mbyte | 1 | |
| 9 maj 2012 kl. 20.20 | Entamöba.jpg (fil) |  |
591 kbyte | 1 | |
| 9 maj 2012 kl. 20.20 | Esbl2.jpg (fil) |  |
783 kbyte | 1 | |
| 9 maj 2012 kl. 20.19 | Esbl1.jpg (fil) |  |
545 kbyte | 1 | |
| 9 maj 2012 kl. 20.19 | Gc.jpg (fil) |  |
410 kbyte | 1 | |
| 9 maj 2012 kl. 20.18 | Gula febern.jpg (fil) |  |
604 kbyte | 1 | |
| 9 maj 2012 kl. 20.18 | Hi.jpg (fil) |  |
488 kbyte | 1 | |
| 9 maj 2012 kl. 17.21 | Cryptosporidium.jpg (fil) |  |
434 kbyte | 1 | |
| 9 maj 2012 kl. 17.20 | Dengue.jpg (fil) |  |
417 kbyte | 1 | |
| 9 maj 2012 kl. 17.20 | Difteri.jpg (fil) |  |
527 kbyte | 1 | |
| 9 maj 2012 kl. 17.13 | VCJD.jpg (fil) |  |
640 kbyte | 1 | |
| 9 maj 2012 kl. 17.11 | Campylobacter.jpg (fil) |  |
275 kbyte | 1 | |
| 9 maj 2012 kl. 17.07 | Brucellos.jpg (fil) |  |
340 kbyte | 1 | |
| 9 maj 2012 kl. 17.03 | GAS.jpg (fil) |  |
517 kbyte | 1 | |
| 9 maj 2012 kl. 16.59 | Botulism.jpg (fil) |  |
365 kbyte | 1 | |
| 9 maj 2012 kl. 16.50 | Atypmykobakt.jpg (fil) |  |
310 kbyte | 1 | |
| 30 april 2012 kl. 12.21 | ESBLx3b.jpg (fil) | |
924 kbyte | 1 | |
| 30 april 2012 kl. 12.02 | ESBL 013.jpg (fil) | |
115 kbyte | 1 | |
| 30 april 2012 kl. 12.01 | ESBL 012.jpg (fil) | |
128 kbyte | 1 | |
| 30 april 2012 kl. 12.01 | ESBL 011.jpg (fil) | |
114 kbyte | 1 |